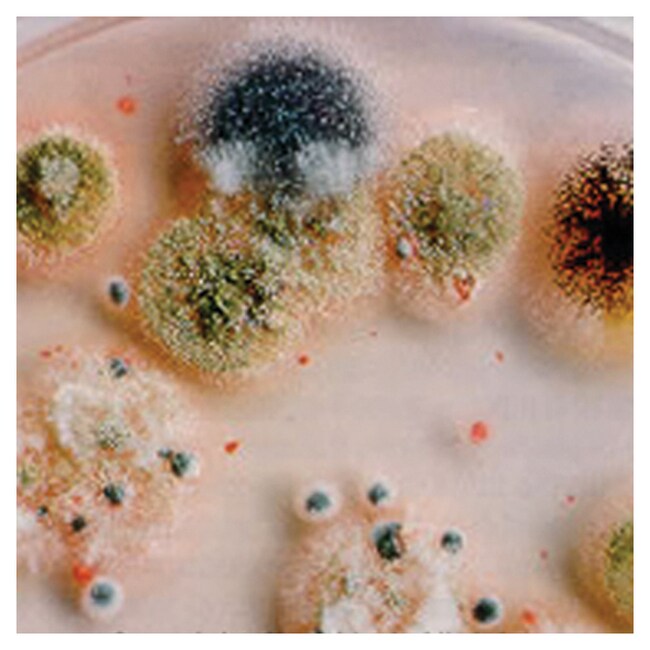

Search
Thermo Scientific™
Dichloran 孟加拉红氯霉素 (DRBC) 琼脂基础(干粉)
采用本款选择性培养基对食品腐败变质相关的酵母和霉菌的分离和计数。
货号 CM0727B
价格(CNY)申请报价
-
使用 Thermo Scientific™ Oxoid™ Dichloran 孟加拉红氯霉素 (DRBC) (ISO) 琼脂基础(干粉),对食品腐败变质相关的酵母和霉菌进行分离和计数。DRBC 琼脂基础经专门设计用以抑制扩散霉菌和细菌的生长,同时又支持无法在孟加拉红氯霉素琼脂或酸化马铃薯葡萄糖琼脂1上分离的菌种的生长。
Dichloran 孟加拉红氯霉素 (DRBC) 琼脂基础是基于 King等人1,2描述的配方,被推荐用于分离和计数在食品腐败中具有重要意义的酵母和霉菌的选择性培养基。
- 易于菌落计数:培养基中的孟加拉红可控制霉菌菌落的大小和高度,防止过度生长并更易于进行菌落计数
- 选择性:适用于从相关菌群(主要由革兰氏阴性杆状细菌组成)食品中分离酵母和霉菌
DRBC 琼脂基础是孟加拉红氯霉素培养基3的改良,不同之处如下:pH 值降至 5.6,孟加拉红含量降低 50%,加入 Dichloran。
这些改良的累积效应是进一步抑制细菌生长,抑制扩散霉菌,如根霉和毛霉,并让培养基能够支持在孟加拉红氯霉素琼脂或酸化马铃薯葡萄糖琼脂1上无法分离的菌种的生长。霉菌扩散的抑制和菌落大小的一般限制,可改善食品腐败变质中产毒霉菌和其他重要菌种的计数和检测6。
部分国家或地区尚未销售赛默飞世尔科技的全部产品。详情请具体咨询。
Remel™ 和 Oxoid™ 产品现已归属 Thermo Scientific 品牌旗下。
一般参考文献:
- King D. A. Jr., Hocking A. D. and Pitt J. I. (1979) J. Appl.& Environ.Microbiol.37.959-964.
- Pitt J. I. (1984) Personal Communication.
- Jarvis B. (1973) J. Appl.Bact.36.723-727.
- Thomson G. F. (1984) Food Microbiol.1.223-227
规格
认证/合规行业参考:NMKL 标准。
描述DRBC 琼脂基础
数量500 g
产量可以配制 15.9 升培养基
形式粉末
产品类型琼脂
Unit SizeEach